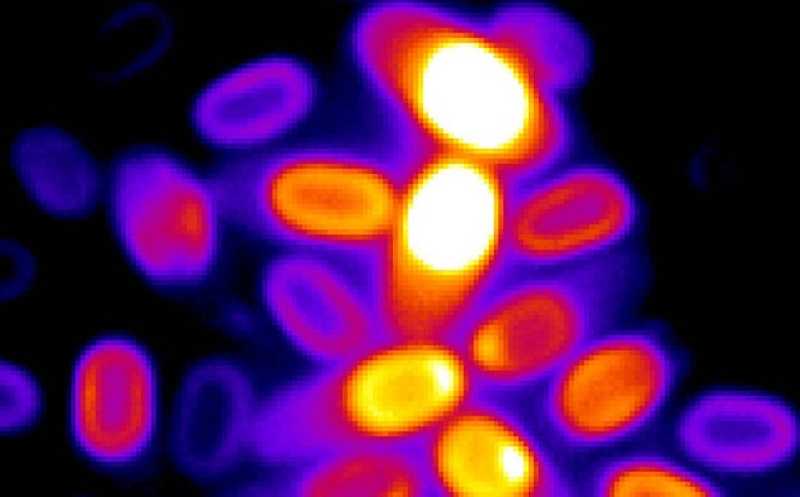

Как покоящиеся споры бактерий понимают, что пора прорастать
Споры сенной палочки могут обрабатывать сигналы внешней среды, не «просыпаясь». Для этого они, подобно нейронам, используют мембранный потенциал, вызванный градиентом концентраций ионов калия. Когда к покоящейся клетке поступают питательные вещества, из нее вытекает все больше калия. При достижении критического порога электрохимического потенциала спора переключается из покоящегося состояния в активное.
Исследователи использовали флуоресцентные красители, чтобы отслеживать изменения электрохимического потенциала на мембране спор Bacillus subtilis
Credit:
K. Kikuchi and Leticia Galera/Suel lab | Пресс-релиз
Сталкиваясь с неблагоприятными условиями, некоторые бактерии образуют споры — останавливают все жизненные процессы и впадают в состояние покоя. Это помогает бактериям выдерживать экстремальные температуры, высокое давление и даже суровые условия открытого космоса. Когда окружающая среда становится подходящей для жизни, споры просыпаются, гидратируясь и перезапуская свой метаболизм. До сих пор ученые не знали, могут ли споры «во сне» следить за изменениями в окружающей среде.
Исследователи из Калифорнийского университета в Сан-Диего изучили тысячи бактериальных клеток и обнаружили, что споры в периоде длительного покоя способны обрабатывать информацию, поступающую извне, чтобы определить, подходят ли условия для возвращения к нормальной жизнедеятельности. Они исследовали сенную палочку, которая образует эндоспоры — клетка делится асимметрично, более крупная дочерняя клетка поглощает меньшую, а затем погибает. В результате цитоплазма споры (ядро, или кор) одета двумя мембранами и споровыми покровами. Авторы рассматривали транспорт ионов через внутреннюю мембрану.
Споры сенной палочки Bacillus subtilis в специальной камере получали короткими импульсами дозы питательных веществ (L-аланина) с интервалом 2 часа. Эксперимент показал, что при каждом воздействии споры сенсибилизируются и приближаются к порогу прорастания.
Ключевая роль потока ионов калия в покоящихся спорах была выяснена с помощью математической модели и мутантных штаммов B. subtilis. Ученые создали штамм сенной палочки с поломанным калиевым транспортёром KtrCD. Отсутствие субъединицы KtrC нарушало транспорт К+ в клетку во время спорообразования, поэтому содержание калия внутри таких спор было меньше, чем у спор бактерий дикого типа. Мутантные споры Δ KtrC прорастали быстрее — это подтвердило предположение о том, что низкая концентрация К+ внутри споры благоприятна прорастанию.
Другой мутантный штамм B. subtilis, ΔYugo, был создан для уточнения роли выходящего калиевого тока. У этих бактерий отсутствовал ионный канал Yugo, отвечающий за выход ионов калия при прорастании споры, следовательно, в таких клетках внутренняя концентрация К+ была постоянно повышена. Поэтому споры ΔYugo были менее чувствительными к импульсам питательных веществ и хуже прорастали, чем споры дикого типа. Похожие результаты были получены при обработке спор блокатором калиевых каналов. Кроме того, когда ученые убирали весь калий из внешней среды, увеличивался выходящий ток калия и споры дикого типа B. subtilis прорастали быстрее.
Направление и сила калиевого тока зависят от градиента концентрации К+ и потенциала на мембране споры. Внутри покоящихся спор содержание ионов калия выше, чем снаружи, и появление питательных веществ во внешней среде приводит к открытию калиевых каналов и оттоку К+ из споры. Поэтому при каждом следующем воздействии понижается электрохимический потенциал и содержание калия внутри споры, что в конечном итоге приводит к её прорастанию.
«Эта работа меняет наше представление о спорах, которые считались инертными объектами», — отмечает Гюрол Сюэль, руководитель работы. Исследователи считают, что новая информация о спорах переосмысливает представления о покоящихся клетках. Результаты позволяют переоценить вероятность существования жизни вне Земли, в том числе на таких объектах, как метеориты.
Бактерии утрачивают спорообразование при адаптации к человеческому кишечнику
Источник
Kaito K. et al. // Electrochemical potential enables dormant spores to integrate environmental signals// Science, 378, 43-49 (2022), DOI: 10.1126/science.abl7484


 Меню
Меню





 Все темы
Все темы




 0
0












